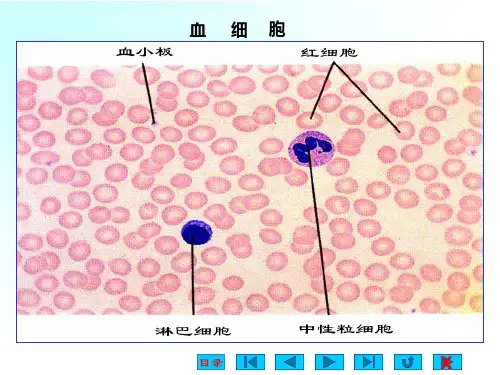

分布值
Scatter 散射性
Mean SD
LY 平均值 分布值
Mean SD
平均值 分布值
MO Mean
SD
平均值 分布值
Mean SD
EO 平均值 分布值
Mean SD
平均值 分布值
.
32
中性粒细胞VCS参数
在诊断急性细菌感染上的运用
.
33
白细细胞胞总大数小增不高,等核,平左均移体,积细偏胞大
162
P<.05
157
P<.0001
152
147
142
137
132
127
MNV
P<.0001
MNC
P<.05 P<.05
Controls Group 1 Group 2 Group 3
MNS
Group 1: WBC < 11,000/uL
Group 2: WBC >= 11,000, but =<
. 15,000/uL
39
Group 3: WBC > 15,000/uL
Mean Channel Number
Neutrophil VCS Parameters in Acute Infection
162 157 P<.0001
P<.0001
152
147
142
137
132
127
122
MNV
MNC
Controls Group A: < 85%
.
13
红细胞体积分布宽度的临床意义
红细胞体积分布宽度(red blood cells volume distribution width 下称 RDW)是反映周围血红细胞体积异质性 的参数,用所测单个红细胞体积的变异系 数来表示(CV=SD/X也可用SD表示)。